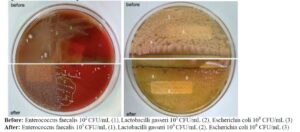

Introduction
In recent years, laser technology has emerged as a minimally invasive treatment option for pelvic floor dysfunctions, particularly for genitourinary syndrome of menopause (GSM) [1–4]. Carbon dioxide (CO2) and Erbium-doped yttrium-aluminum-garnet (Er:YAG) lasers deliver short pulses that raise vaginal mucosal temperatures to 60–70 °C, promoting vaginal remodeling, neocollagenesis, and neovascularization [5–7]. These processes help restore vaginal mucosal elasticity and muscle tone [2]. Fractional CO2 laser therapy creates micro-perforations in the vaginal mucosa, stimulating healing in the treated microzones and promoting tissue regeneration and tightening [5,8]. Unlike ablative CO2 lasers, the non-ablative smooth mode of Er:YAG does not injure the mucosa; it delivers controlled heat to the lamina propria without ablating or damaging the mucosal surface or underlying structures [6,7].
Laser therapy also affects the vaginal epithelium and helps restore its functionality, creating a suitable environment for a healthy vaginal microbiome [9]. The vaginal microbiome consists of numerous microorganisms, collectively known as the microbiota, which is dominated by lactobacilli and exists in a mutually beneficial relationship with the vaginal epithelial cells. Together, they form the vaginal mucosal ecosystem, providing protection against pathogen invasion, colonization, and inflammation [10–12]. The composition of the vaginal microbiome is dynamic and changes in response to hormonal fluctuations, sexual activity, antibiotic use, stress, and other factors [10]. However, the direct effect of laser exposure on a healthy vaginal microbiome remains unknown.
Neodymium-doped yttrium-aluminum-garnet (Nd:YAG) laser with a wavelength of 1,064 nm does not damage the epithelial surface, similar to the smooth-mode Er:YAG laser. With its long pulses and durations in the range of seconds (piano mode), the Nd:YAG laser gently heats deeper structures, including the dermis, subcutaneous fat, and muscles [1,13]. The piano mode has been successfully applied in gynecological treatments for conditions such as vulvodynia associated with lichen sclerosus [14], dyspareunia [15], chronic pain in women with interstitial cystitis [16], and vaginal atrophy [17]. Combined vaginal Er:YAG and vulvar Nd:YAG laser therapies have been shown to be significantly more effective in improving vulvar pain and superficial dyspareunia compared to vaginal Er:YAG alone [15]. Adding a neodymium laser to an erbium laser for vulvar treatment provides greater benefits than using Er:YAG or Nd:YAG alone for symptom resolution in women with lichen sclerosus [18]. However, no studies have reported the use of a neodymium laser for intra-vaginal treatment. Furthermore, the effect of combined laser treatment of the vulva and vagina on GSM-related symptoms has not been investigated. The aim of this study was to assess the safety, acceptability, and effectiveness of non-ablative vaginal and vulvar Nd:YAG laser in piano mode and Er:YAG laser in smooth mode in patients with GSM, and to investigate their direct effect on the vaginal microbiome.
Methods
Study design and patients
This pilot, prospective, comparative study involving sexually active women was conducted at Dr. Pustotina’s Clinic in Moscow, Russia, from May to July 2025. The study followed the principles of the Helsinki Declaration and was approved by the Ethics Committee of the Private Educational Institution of Supplementary Education “Inosemtsev Academy of Medical Education” (protocol № 2-2025, 28.05.2025). After providing written informed consent, 20 women aged 45–70 years, diagnosed with GSM, were enrolled.
Patients underwent a single session of vaginal and vulvar laser treatment using the Fotona laser system (SP Dynamis, Slovenia). Ten women received treatment with a 2,940 nm Er:YAG laser applied in non-ablative smooth mode (Er:YAG group). The other 10 women were additionally treated with a 1,064 nm Nd:YAG laser in piano mode immediately prior to Er:YAG laser treatment (Nd/Er:YAG group). Both laser treatments were performed consecutively within the same session without any interval between the two exposures. Procedures were performed on an outpatient basis without any pre- or post-treatment medications. Following treatment, all patients were instructed to avoid the use of antimicrobial drugs for 7 days.
Exclusion criteria included positive Pap smear results; active genitourinary tract infection; sexually transmitted infections; abnormal uterine bleeding; history of photosensitivity disorders or use of photosensitizing medications; severe genital prolapse (grade ≥ II according to the Pelvic Organ Prolapse Quantification system); severe urinary incontinence; or any serious or chronic illness that could interfere with study participation or outcomes. Women with contraindications to laser therapy, including epilepsy, pregnancy, or acute systemic infection, were also excluded.
Laser treatment
Nd:YAG laser
The Nd:YAG laser (1,064 nm) was set to piano pulse mode with a pulse duration of 5 s and a fluence of 110 J/cm². The procedure consisted of two steps:
- After insertion of a glass vaginal speculum, the R33 handpiece with a 9 mm spot size and an angular GA adapter, connected via a dedicated adapter designed by Peter Regenyi, was introduced through the speculum without direct contact with the vaginal mucosa. The vaginal wall was irradiated from the proximal to the distal end by delivering laser energy while withdrawing the probe at a speed of 5 mm/s. Four passes were performed at each angular mirror position, moving clockwise from the 12 o’clock to the 11 o’clock position. Prior to speculum insertion, the vaginal walls were dried. No topical antiseptics were used.
- The vaginal speculum was then removed. The introitus and entire vulvar area were irradiated using the R33 handpiece with a 9 mm spot size and the same laser settings as in step 1. Six to eight passes were performed in brushing mode until the skin surface temperature reached 39–40 °C.
Er:YAG laser
The Er:YAG laser (2,940 nm) was set to smooth mode with a fluence of 7.0 J/cm², pulse duration of 250 ms, spot size of 7 mm, and frequency of 2.5 Hz. The procedure consisted of two steps:
- After insertion of a specially designed glass vaginal speculum, the R11 handpiece with a 360° circular GA adapter was introduced through the speculum, providing circumferential irradiation of the vagina along its entire length (four pulses every 5 mm, four passes). Prior to speculum insertion, the vaginal walls were dried. No topical antiseptics were used.
- The vaginal speculum was then removed. The introitus and entire vulvar area were irradiated using the PS03X handpiece with a 7 mm spot size, frequency of 2.5 Hz, and pulse fluence of 7.0 J/cm². Four passes were performed in brushing mode over the vulva. Before laser exposure, a thin layer of water-soluble, colorless gel commonly used for ultrasound scanning was applied to the vulvar skin and mucosa.
Assessment methods
Symptom evaluation
All patients were asked to assess the presence and severity of five vaginal symptoms before the laser procedure, immediately after treatment, and one-week post-treatment using an 11-point visual analog scale (VAS), where 0 indicated “absence of symptom” and 10 indicated “intolerable symptom.” The symptoms evaluated were dryness, burning, itching, pain (including dyspareunia and/or vulvodynia), and abnormal vaginal discharge.
Vaginal sample collection
Vaginal samples were collected before and immediately after the laser procedure. DNA extraction and PCR analyses were performed at NanoDiagnostics LLC (Moscow), while microscopic examination of vaginal smears and culture tests were conducted at LabQuest Laboratory (Moscow).
Microscopic examination of methylene blue-stained vaginal smear
Microscopic examination was performed to identify microorganisms, assess epithelial cell integrity, and detect living or dead yeast cells. Bacterial morphotypes and host cells (epithelial cells, erythrocytes, and leukocytes) were counted and evaluated using a Carl Zeiss Primo Star microscope (Germany) equipped with an oil immersion objective at 100× magnification.
DNA extraction and quantitative PCR analysis
DNA was extracted from vaginal samples using the MagnoPrime® FAST kit (NextBio, Russia) according to the manufacturer’s instructions. Microbial composition was analyzed using polymerase chain reaction (PCR) with the following AmpliPrime® FLOROSCREEN® reagent kits: Bacterial Vaginosis, Aerobes, Candidae, and Mycoplasma, as well as the AmpliPrime® LACTOSCREEN® kit (NextBio, Russia).
The FLOROSCREEN® Bacterial Vaginosis kit detects and quantifies Gardnerella vaginalis, Atopobium vaginae, and Lactobacillus spp., providing the total bacterial load expressed as the total bacterial mass (TBM). The FLOROSCREEN® Aerobes kit quantifies DNA from enterobacteria (Enterobacteriaceae family, including Escherichia coli, Klebsiella spp., Proteus spp.), staphylococci (Staphylococcus spp.), and streptococci (Streptococcus spp.). The FLOROSCREEN® Candidae kit targets fungal DNA from Candida spp., including C. albicans, C. glabrata, C. krusei, C. parapsilosis, and C. tropicalis, while the FLOROSCREEN® Mycoplasma kit quantifies Ureaplasma parvum, Ureaplasma urealyticum, and Mycoplasma hominis. The LACTOSCREEN® kit detects and quantitatively determines DNA from Lactobacillus iners, L. gasseri, L. crispatus, and L. jensenii, with relative lactobacilli content expressed as the lactobacilli index (LI), representing the proportion of total lactobacilli to TBM.
PCR amplification was performed in 30 μL reaction volumes, including 10 μL of template DNA, using a Bio-Rad CFX96 Real-Time PCR System.
Culture Test
Microbiological culture studies were performed using nutrient media and supplements from BioMérieux (France), Oxoid (UK), Liofilchem (Italy), and locally produced media. Media preparation and dispensing into Petri dishes were carried out with the MasterClave 09 Media Preparation automatic dispenser and the APS ONE filling module (BioMérieux, France). Quality control procedures verified sterility and growth characteristics. Reference strains from the ATCC collection were used to assess growth performance: Staphylococcus aureus ATCC 25923, Escherichia coli ATCC 25922, and Pseudomonas aeruginosa ATCC 27853.
Primary cultivation of vaginal samples was performed on 1.5% blood agar based on Columbia agar (BioMérieux, France) supplemented with CNA (Liofilchem, Italy) for detection of Gram-positive bacteria, including staphylococci (S. aureus), streptococci (pneumococci and pyogenic streptococci), enterococci, corynebacteria, and other Gram-positive rods. (Oxoid, UK) was used to isolate and differentiate lactose-fermenting and nonfermenting MacConkey agar Gram-negative enterobacteria, as well as nonfermenting bacteria such as pseudomonads and Acinetobacter species.
Initial plating employed the four-quadrant streaking method, followed by subculturing. Incubation was conducted at 37°C for 24–48 hours, either in a normal atmosphere using an INCUCELL incubator (BMT, Czech Republic) or under increased CO₂ using an MCO-19AIC incubator (Sanyo, Japan).
Adverse events
Adverse events were monitored continuously throughout the procedure and during the one-week follow-up period.
Patient Satisfaction
Overall treatment satisfaction was assessed using a 5‐point Likert scale (1 = very unsatisfied, 2 = unsatisfied, 3 = neutral, 4 = satisfied, 5 = very satisfied).
Statistical analysis
Data analysis was performed using Statistica 13.3 software (StatSoft Inc., USA). Normally distributed variables are presented as median and interquartile range (Me [Q25; Q75]). Quantitative indicators were compared using Student’s t-test for normally distributed data or the Mann–Whitney test for non-normal distributions. Changes over time were analyzed using paired Student’s t-test for normally distributed data or the paired Wilcoxon test for non-normal data. Qualitative variables were compared between groups using the Chi-square test or the two-sided Fisher exact test. Changes in binary parameters during treatment were evaluated using the McNemar test. Statistical significance was accepted at p < 0.05.
Results
Bothersome symptoms
There were no significant differences between the treatment groups in age, body mass index (BMI), hormonal status (premenopausal or menopausal), or smoking (Table 1). Baseline severity and frequency of bothersome symptoms were also similar between groups (Table 2, Figure 1). Symptom severity was measured on a 0–10 visual analog scale (VAS), with predominant complaints being dryness (80%) and pain (75%).
On the day after the laser procedure, significant improvement in symptoms was observed in both groups, and 65% of patients reported no complaints one week after treatment. More pronounced improvement was observed in the Nd/Er:YAG group. Although differences between groups did not reach statistical significance due to the small sample size, combined laser treatment demonstrated a more beneficial effect in symptom resolution. Sixty percent of patients in the Nd/Er:YAG group had no complaints the day after the procedure, compared to 40% in the Er:YAG group. Immediately after the procedure, pain was completely resolved in 7 out of 8 women (87.5%) in the Nd/Er:YAG group, compared to 4 out of 7 (57.1%) in the Er:YAG group.
Patient Satisfaction
Overall patient satisfaction was assessed using a 5-point Likert scale. All patients reported being very satisfied (75%) or satisfied (25%) with the laser treatment. Higher satisfaction scores (5 points) were more frequent in the Nd/Er:YAG group than in the Er:YAG group (90% vs. 60%, respectively).
Adverse effects
No adverse events related to the procedure were recorded throughout the study. The most common reaction was a mild sensation of warmth during vulvar treatment, without burning or soreness. One patient in the Er:YAG group experienced dryness for one day after the procedure.
Microscopic examination of methylene blue-stained vaginal smear before and after laser treatment
Vaginal smears were obtained immediately before and after the laser procedure in all patients. Methylene blue staining was used to identify microbial morphotypes, count host cells, and assess possible cell damage. All smears contained superficial epithelial cells, and 55% also showed parabasal cells. No differences were observed before or after the laser procedure or between laser modes. Basal cells, cellular lysis (bare nuclei and cytoplasm debris), clue cells, erythrocytes, or inflammation (more than 10 leukocytes per field) were not detected. Bacterial morphotypes consisted of lactobacilli (90% of samples before and 85% after laser) and mixed bacteria (60% and 50%, respectively). No yeast blastospores or mycelium were detected.
PCR analysis before and after laser treatment
Quantitative PCR demonstrated bacterial DNA loads ranging from 1.33 × 10⁴ to 9.37 × 10⁵/mL, with Lactobacillus spp. DNA ranging from 1.00 × 10⁴ to 3.95 × 10⁵/mL. Both groups showed a significant decrease in total bacterial mass (TBM) and Lactobacillus spp. after laser treatment, with TBM decreasing from a median of 30 (8.0–40.0) × 10⁴ to 6 (3.5–9.0) × 10⁴ (p = 0.006), and Lactobacillus spp. decreasing from 7 (1.0–25.0) × 10⁴ to 3 (1.0–5.0) × 10⁴ (p = 0.047). This reduction may be partially attributed to drying of the vaginal walls with a cotton swab prior to laser application, which removed vaginal discharge and significantly reduced the total number of cells in the samples from 40 (8.0–60.0) × 10⁴ to 8 (3.0–20.0) × 10⁴ (p = 0.004).
Microbiome diversity did not change, as the predominance of individual microbial species remained similar before and after laser treatment (p > 0.05, Table 3, Figure 2), except for a decrease in Gardnerella vaginalis in the Er:YAG group, likely due to the same mechanical effect.
The LI, indicating the proportion of lactobacilli in the TBM, ranged from 1.4% to 100%. LI = 100% did not indicate absence of other bacteria but that their quantity relative to lactobacilli did not exceed 1%. Most samples (55%) at baseline showed dominant lactobacilli species (LI > 50%), which remained unchanged after laser treatment. The relative abundance of L. crispatus, L. gasseri, L. jensenii, and L. iners did not differ after laser application (Figure 3).
PCR cannot distinguish DNA from live versus dead cells post-laser exposure. Therefore, culture tests were performed to clarify microbial viability.
Culture test before and after laser treatment
Culture studies were conducted in five women from each group. All baseline samples were culture-positive (Table 4). The study aimed to assess whether microorganisms able to grow before the procedure remained viable after laser exposure, rather than to characterize the entire vaginal microbiome.
Lactobacilli growth (10⁴–10⁶ CFU/mL) was observed in 8 out of 10 patients post-laser. L. crispatus was detected in 6 patients, L. gasseri in 4, and L. iners in 3; all maintained viability after laser exposure. Similar trends were observed for non-lactobacillus microbiota: Enterobacteriaceae, Streptococcus spp., and C. albicans were cultured in 80% of patients (10²–10⁶ CFU/mL) both before and after laser application.
A positive culture does not distinguish colonization from infection. Despite high pathogen concentrations, the absence of abnormal vaginal discharge within a week post-treatment suggests that the laser procedure did not adversely affect, and may have supported, vaginal mucosa protection against infection and inflammation.
Microscopy of methylene blue-stained smears and culture results from a 45-year-old patient before and after Nd/Er:YAG laser treatment are shown in Figures 4 and 5.
Discussion
This is the first study to evaluate the effects of vaginal application of Er:YAG laser in a smooth mode and Nd:YAG laser in a piano mode on the vaginal microbiome. We were also the first to use the Nd:YAG laser in a piano mode inside the vagina, utilizing a special adapter between the R33 handpiece and the GA-adapter. Our aim was to provide data on the short-term effects of combined laser exposure on GSM symptoms and to obtain patient feedback on treatment satisfaction.
All patients underwent laser treatment of the vulva and vagina using the Er:YAG laser in smooth mode, and half of them were additionally treated with the Nd:YAG laser in piano mode. Both modalities effectively alleviated GSM symptoms, with 50% of patients reporting no complaints immediately or one day after treatment, while the remaining participants experienced substantial symptom reduction. It is essential to treat the entire vulvar area during the procedure, as atrophic changes in the skin and mucosa of the vulva (including the introitus) contribute to complaints such as dryness, burning, itching, and pain.
Although no statistically significant differences were observed between treatment groups due to the small sample size, combined laser treatment appeared to have a more pronounced effect on symptom resolution, particularly pain relief. Pain, including dyspareunia and vulvodynia, was a predominant symptom alongside dryness, and resolved completely immediately or one day after treatment in 87.5% of patients in the Nd/Er:YAG group compared to 57.1% in the Er:YAG group. These findings are consistent with previous studies supporting the use of Nd:YAG laser in piano mode for women experiencing chronic pelvic pain [14–18], and suggest potential benefit for breast cancer survivors who have previously received vaginal Er:YAG laser alone [19–22].
Procedure comfort is also an important consideration. The Nd:YAG laser in piano mode allows thermal diffusion without peaks in surface temperature, making it painless [1,13], whereas Er:YAG laser in smooth mode may cause mild soreness. Moisturization of the vulvar skin prior to Er:YAG treatment further enhances comfort, as reflected by high patient satisfaction in this study and in our previous work [23]. No adverse events were observed during the study.
The primary objective of our study was to assess the direct effects of laser irradiation on the vaginal microbiome. Vaginal samples were collected immediately before and after treatment and analyzed using methylene blue staining, PCR, and bacterial culture, providing a comprehensive evaluation of microbial shifts induced by laser application.
Microscopic examination of vaginal smears revealed no epithelial damage, bleeding, or inflammation following laser treatment. Lactobacilli were present in 90% of baseline samples and 85% post-laser, suggesting that the applied laser modes did not negatively affect the vaginal mucosal epithelium. Maintaining an intact epithelial layer rich in glycogen is essential for the vitality of Lactobacillus spp. and for vaginal health.
Molecular analysis by PCR demonstrated a significant reduction in total bacterial mass (TBM) after laser treatment, while microbiome diversity remained unchanged. The observed decrease in microbial cell numbers is likely due to partial removal of vaginal discharge during sample collection, rather than a laser-induced effect. No significant differences were observed in the relative abundance of Lactobacillus species, and the proportion of lactobacilli within the total bacterial population remained stable. This preservation is crucial for maintaining a healthy vaginal microbiome [24].
A key challenge was distinguishing DNA from live versus dead microorganisms. Cultivation of vaginal samples indicated that all initially identified bacteria, particularly lactobacilli, retained the ability to grow after laser exposure. Furthermore, laser treatment appeared to support mucosal protection against infection and inflammation, as no abnormal vaginal discharge was observed within a week post-treatment, even in the presence of high pathogen loads. These findings align with a recent multicenter study of 167 women with recurrent vulvovaginal candidiasis [25], in which non-ablative vaginal Er:YAG laser treatment improved symptoms and reduced Candida albicans prevalence from 80% to 30%, with complete pathogen elimination in 64% of women nine months after treatment.
Overall, these results indicate that laser treatment positively affects vaginal epithelium, restoring its function and creating a favorable environment for a healthy vaginal microbiome. This study demonstrates, for the first time, the effectiveness, safety, and high patient satisfaction of combined vulvar and vaginal Nd:YAG piano-mode treatment for GSM. When combined with Er:YAG smooth-mode laser, the Nd:YAG laser provided greater symptomatic relief, including improvements in dryness, burning, itching, pain, and vaginal discharge. Importantly, both laser modalities appeared safe for the vaginal mucosal epithelium and did not alter vaginal microbial composition.
Study limitations
The main limitations of this study were the small sample size and short follow-up period, which preclude conclusions about long-term effects. Symptom assessment relied solely on the VAS score; incorporating the Vaginal Health Index and Vulvar Health Index could enhance evaluation of treatment effectiveness. Additionally, vaginal samples were not analyzed immunologically, limiting assessment of laser thermo-diffusion effects on mucosal protective function.
Conclusion
This pilot study demonstrates that combined Nd/Er:YAG laser treatment of the vulva and vagina is a safe, effective, and minimally invasive approach for women with GSM. Both the Nd/Er:YAG combination and Er:YAG smooth-mode laser preserve the vaginal mucosal ecosystem and lactobacilli dominance. The addition of Nd:YAG piano-mode application may prevent unwanted infections, support vaginal microbiome regulation, and serve as an adjunct to standard treatments for vaginal dryness, relaxation syndrome, painful sexual function due to atrophy, and urinary incontinence. This approach may also benefit breast cancer survivors who cannot undergo hormonal therapy, representing a promising option for alleviating GSM symptoms and stimulating further research.
Declarations
Abbreviations
Nd:YAG: neodymium-doped: yttrium aluminum garnet; Er:YAG: erbium-doped: yttrium aluminum garnet; VAS: Visual Analog Scale; LI: lactobacilli index; TBM: total bacterial mass; PCA: polymerase chain reaction; GSM: genitourinary syndrome; BMI: body mass index.
Ethics approval and consent to participate
The study was conducted in accordance with the Declaration of Helsinki and approved by the Ethic Committee of Private Educational Institution of Supplementary Education “Inosemtsev Academy of Medical Education” (protocol № 2-2025, 28.05.2025). Written informed consent was obtained for all participants.
Consent for the publication
All the patients had given a written informed voluntary consent to participate in the study and publish their data.
Availability of data and material
The data that support the findings of this study are not publicly available due to privacy reasons but are available from the corresponding author upon reasonable request.
Competing interests
The authors declare no conflict of interest and guarantee that the article is their original work.
Author contributions
Pustotina O, Demkin V: collection of clinical data and creation of an electronic database for the results, analysis of the results of statistical processing of the clinical material and their interpretation, writing, correcting, and editing of the article before the publication. Regenyi P, Erel T, and Vizintin Z: writing, correcting, and editing of the article before the publication. All authors read and approved the final manuscript.